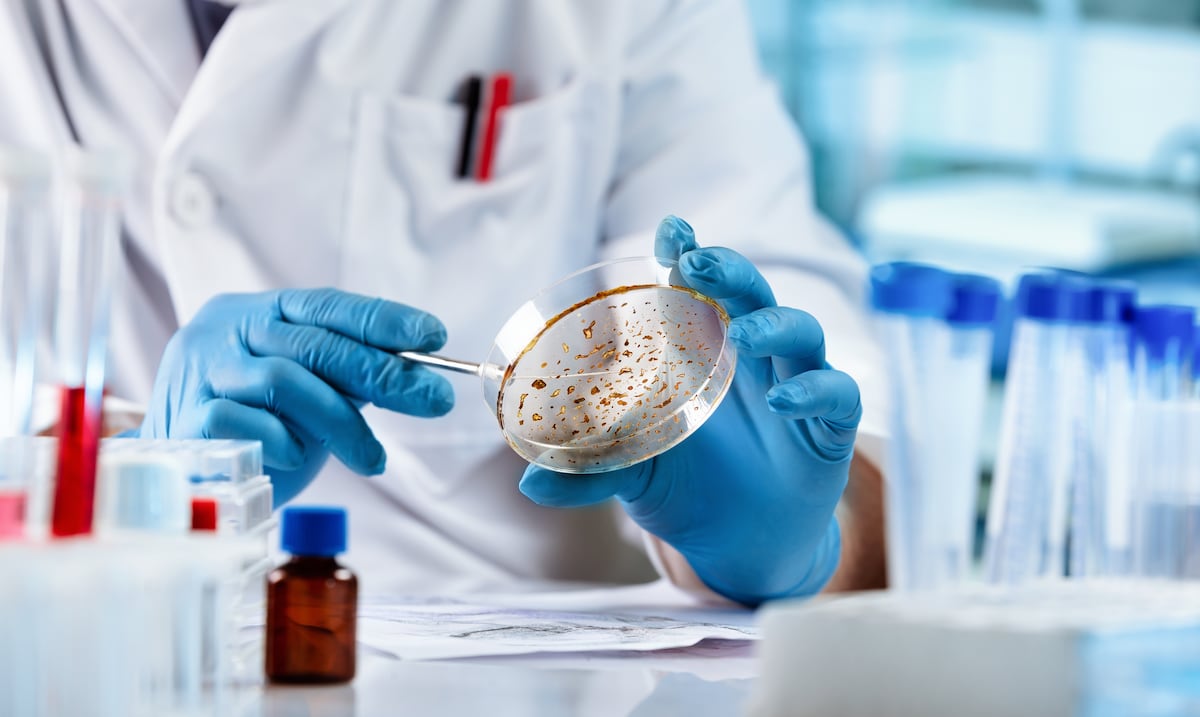
Opinión | Un rayo de esperanza en la lucha contra el cáncer

Opinión | El poder del ambiente físico en el mundo corporativo
OpiniónExplica ideas y extrae conclusiones basadas en la interpretación de hechos y datos.Para atraer y retener es importante que el ambiente de trabajo pueda cumplir con parámetros donde el entorno físico y sensorial tenga un